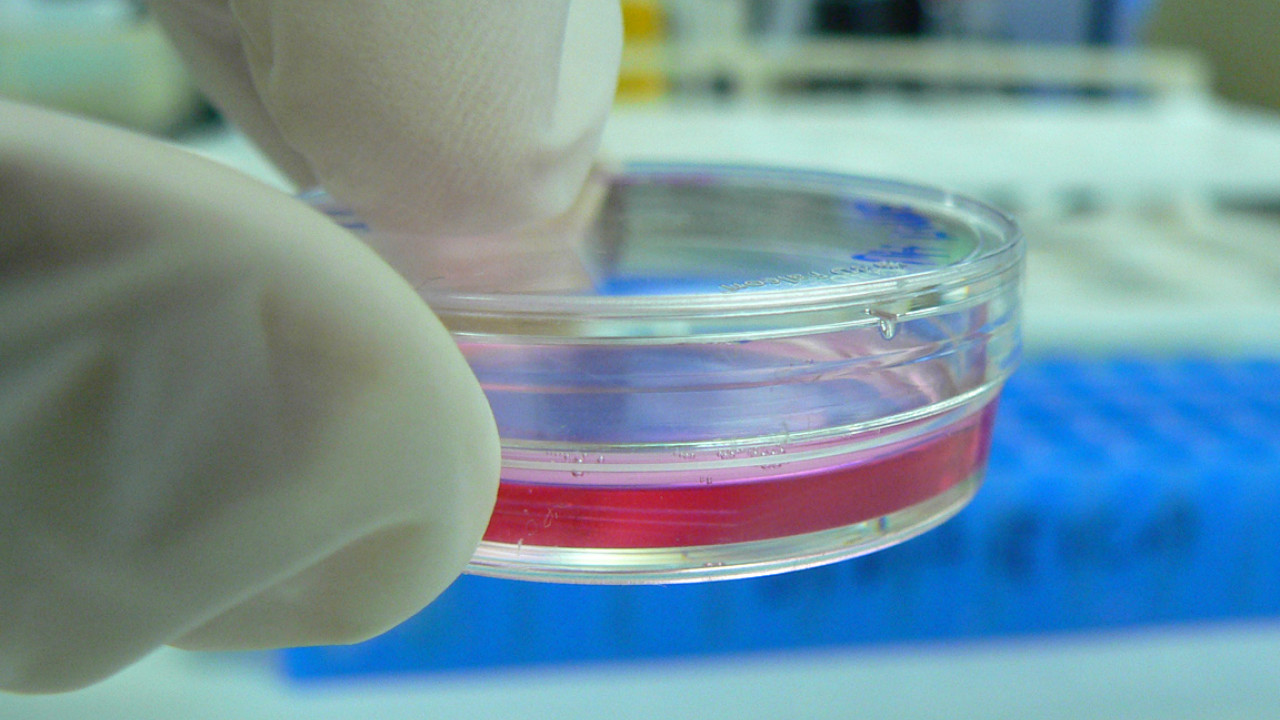

Δοκιμάστηκε ως συμπληρωματικό εργαλείο στη δουλειά των γιατρών μίας περιφερειακής ενότητας του NHS και ανέλυσε τις μαστογραφίες περισσότερων από 10.000 γυναικών
Λονδίνο, Θανάσης Γκαβός
Ένα εργαλείο Τεχνητής Νοημοσύνης που δοκιμάστηκε στο βρετανικό δημόσιο σύστημα υγείας NHS αναγνώρισε με επιτυχία μικροσκοπικές ενδείξεις καρκίνου του μαστού σε 11 γυναίκες, το πρόβλημα των οποίων δεν είχε ανιχνευθεί από τους γιατρούς.
Το εργαλείο φέρει το όνομα Mia. Δοκιμάστηκε ως συμπληρωματικό εργαλείο στη δουλειά των γιατρών μίας περιφερειακής ενότητας του NHS και ανέλυσε τις μαστογραφίες περισσότερων από 10.000 γυναικών.
Το εργαλείο κατάφερε να αναγνωρίσει όλες τις περιπτώσεις με καρκινικό όγκο συν τις έντεκα που είχαν διαφύγει των γιατρών.
Με τον τρόπο αυτό φαίνεται πως η Τεχνητή Νοημοσύνη μπορεί να ανιχνεύει τον καρκίνο σε πραγματικά πολύ αρχικό στάδιο, όταν ο όγκος είναι σχεδόν αόρατος στο ανθρώπινο μάτι. Ωστόσο, η δοκιμή ήταν η πρώτη και πολύ περιορισμένης έκτασης.
Σε μία από τις έντεκα περιπτώσεις, ο όγκος είχε διάμετρο έξι χιλιοστών. Ο έγκαιρος εντοπισμός από το εργαλείο Mia συνέβαλε στο να χρειαστεί η ασθενής μόνο πέντε ημέρες ακτινοθεραπείας μετά από την επέμβαση στην οποία υποβλήθηκε.
Πηγή: skai.gr



































